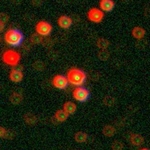
olives in space

New to Galaxy Zoo? Want Help? Read this!
-
 by
vrooje
admin, scientist
by
vrooje
admin, scientist
This is meant to help anyone who has questions about what to discuss on Galaxy Zoo Talk, and how to do it. There are some questions that come up pretty frequently, and some people have said they'd like to know what kinds of things they should be looking for. Below may not be an exhaustive list, but it's an attempt. If you have any questions please feel free to contact me or post a response.
Tutorial
We're currently updating the extended tutorial, so watch this space -- in the meantime I hope the information below will do.Classifying
Always classify the central object. We ask many people to classify the same object, so we get a really good idea of how confident people were and therefore how easy to classify an object was. There's often no right answer, so just use your judgment and give us your best guess. And thank you!Weird Stuff
If you came here to ask "what the heck is that?!" about something you've just seen, chances are it might be an artifact of some kind, or a normal object (like a star) that just looks weird. Here are examples of some common ones:
AGZ0002k6n, AGZ0001wnp
Something went weird with the focus/imaging: these are stars, believe it or not. #artifact

AGZ0002j99, AGZ0002jvw
There is a very bright star just outside this image and its light is spilling over into the frame. (Also, the image is partly cut off.) #artifact



AGZ00008ey, AGZ0003492, AGZ0003vrz, AGZ0001o4y
Now the stars are all in the frame and look pretty weird. Some of these look weird because they're so bright. In general, the image creation is optimized to show galaxies in their best light, not stars, so stars often look a bit... well, like the above. #star #artifactNote it's quite common to see stars in front of galaxies, in which case that's a #foregroundstar.


AGZ00058eo, AGZ0003q65
Satellites sometimes pass overhead as the telescope is observing and reflect light in a streak across the image as they pass by. They move quickly so their trails are always a single color: red, green, or blue. Sometimes you can classify the central galaxy, other times there is no central galaxy because the computer got a bit confused. (Also, the one without a galaxy in it has a #star off to the side.) #satellitetrail

AGZ00059k0, AGZ0003z60
Asteroids also move across these images, albeit more slowly than satellites. So when each of the filters that make up the image colors takes data in succession, the asteroid looks like a multicolored stripe (or series of dots) across the image. You can usually classify the galaxy too, but this is interesting extra information. Note: the first example also has a #foregroundstar over the top of a lovely #edgeon galaxy. #asteroid

AGZ000005o, AGZ0000001 <-- wait, really? 0000001? cool.
Sometimes the very edges of a camera chip have bad pixels. Sometimes you can still classify the central galaxy. Other times, not. #edgeofchip #artifactPlus, there are lots of other weird things. Other examples (hover your mouse over the image to see my comments):






AGZ0001u10, AGZ0000qos, AGZ0004fu5, AGZ0001tzy, AGZ00035f5, AGZ0001txq
If you see something you've never seen before but that you suspect is weird, feel free to ask whether it's an artifact or not. If you'd like to see some other artifacts, check out these collections: CGZS0000gw, CGZS000119Now that you've seen this page you can just tag them using the hashtag system.
Science Bonuses
Galaxy Zoo volunteers are brilliant at finding weird and wonderful things we didn't expect. So we often want to keep track of objects with properties we don't ask about in the main classification questions. If you spot one of these kinds of objects you can help us by tagging it!Overlaps and Mergers
Some galaxies that are close together on the sky are actual galaxy #mergers. Others are just coincidences, and sometimes the galaxies actually appear to #overlap on the sky. We can learn really interesting things about galaxies by looking at the ones that overlap! It can be difficult to decide whether two galaxies are interacting or are just overlapping, but if you suspect one or the other please do tag it! What do you think of these examples?




AGZ00054qy, AGZ0002baz, AGZ0002iue, AGZ0001us4
Voorwerpjes
Ever since the discovery of Hanny's Voorwerp we've been looking for more examples of ionized gas clouds in or near galaxies. They show up as brightly colored patches that don't really follow the rest of the shape of the galaxy, and we're on the hunt for more! Here are some examples of galaxies recently marked with the #voorwerpje tag: what do you think?






AGZ0001xbb, AGZ0005ks2, AGZ0003g4y, AGZ00008gk, AGZ0002244, AGZ00059zp
Bulgeless AGN
We're looking for pure disk galaxies with no bulge but that host an AGN.
........."Wait, what's an AGN?"
An Active Galactic Nucleus is the term for a supermassive black hole in its "on" state: it's actively growing, which means the region around it (which is very compact) is also radiating. It can be very bright. AGN are tricky to spot just by looking at an image, but often they look like stars (sometimes very bright stars) superimposed right over the middle of a galaxy. It's okay to mark it if you just suspect there might be one -- don't worry, we'll follow up and check for sure!Disk galaxies without bulges are of special interest because they have evolved without undergoing any of the processes that lead to the formation of bulges (including mergers). But those formation processes are the means by which supermassive black holes supposedly grow most of the time. So finding a growing black hole in a bulgeless galaxy is really interesting.
If you spot one (and here are a few candidates), feel free to tag it as #bulgeless #AGN or even #bulgelessAGN:




AGZ0001gvd, AGZ000289a, AGZ00041mq, AGZ0003h9a
And, of course, even if you aren't sure there's an AGN, you can always tag a #bulgeless galaxy.
Other Stuff
Perhaps the best part about Galaxy Zoo is that a new discovery is potentially just around the corner at any given moment. If you see something you don't see described here, just ask! Leave a comment on the object's page, or start a discussion about it. And if you have any other questions, please feel free to ask any member of the team, or a moderator. Feel free to send me a private message if you have questions you can't find the answer to elsewhere on Talk!And feel free to add to this too -- this project is always changing so I expect new science goals to be added and new artifacts discovered at any time.
Cheers,
-Brooke (vrooje)Posted
-
 by
Padme-1
by
Padme-1
Thank you so much Brooke (vrooje). I have been exploring Zooniverse since January of this year and am just thrilled with the site.The information you have shared is so wonderful! A big help to me for some of the areas I was not familiar with. - Thank you,Stephanie (Bajik)
Posted
-
 by
Half65
by
Half65
Another valuable font of information and help is the Forum
Posted
-
 by
Innerspace
by
Innerspace
Yep, I must agree this helps a lot T-Y. I find it fasinating to see things that very few have seen and to be 'helping' that is a added bonus.
Posted
-
 by
icarus777
by
icarus777
Thanks everyone. I enjoy the viewer based forums because no matter the level of education, everyone has an interesting investigative approach being their own view point, their thirst for curiosity, and their pursuit of unknown answers. I have missed doing research with me being an old guy now!
Posted
-
 by
suelaine
by
suelaine
A lot of the galaxies that I investigate have a designation of "ugs" such as this very interesting galaxy "ugs_07812". What does that mean and where does it come from? Thanks
Sue Morris...SuelainePosted
-
 by
ElisabethB
moderator
in response to suelaine's comment.
by
ElisabethB
moderator
in response to suelaine's comment.
Hi Sue
UGC is one way of making a catalogue of galaxies
Here's what wiki has to say about it : http://en.wikipedia.org/wiki/Uppsala_General_Catalogue
Posted
-
Anyone else having trouble with the electric blue type? The info. is great but wish I would have known all this before I started. For beginners, it's confusing where to leave a question and really assumes a high level of computer literacy (which is probably understandable given the topic of astronomy). Would help if I could blow up the pix I'm classifying. (see, it's probably super easy to do, I just don't know how!)
Posted
-
 by
fatha731
in response to still christine's comment.
by
fatha731
in response to still christine's comment.
If I understand you correctly, you're having problems with low quality pictures and don't know where to ask your questions?
Posted
-
 by
khasab
by
khasab
The link to the tutorial describing how Talk works doesn't seem to be working or it takes me to a blank page.
Posted
-
 by
vrooje
admin, scientist
in response to khasab's comment.
by
vrooje
admin, scientist
in response to khasab's comment.
Good point -- that was the old version and the new version is coming soon. I'll update the link as soon as it's online! Thanks.
Posted
-
 by
3Maceo3
by
3Maceo3
Greetings all,
I'm new to Zooniverse and I was curious if I find a galaxy can I name it like people do with stars? Like can I name it officially, so when people refer to the galaxy they use the name that I created?
I'm relatively new to astronomy but I'm intrigued and eager to learn all that I can. The universe is unlimited and Earth is in the universe and I'm on Earth so that means I'm unlimited in the amount that I can learn right?!?!?!
I'm kind of new on here and haven't marinated fully on the "Read this" info, so if anyone can answer my question about the naming thing it would be great! Thanks in advance 😃
Posted
-
 by
ElisabethB
moderator
by
ElisabethB
moderator
Hi 3Maceo3,
Welcome to the Zoo. Hope you'll have a great time here.As for officially naming galaxies, sorry, that is not possible. The same goes for stars. But you can always name a galaxy, just for fun. 😄
Happy Hunting !
Els
Posted
-
 by
christophers
by
christophers
How do you change a password on this site? I can't find the option anywhere?
Posted
-
 by
fatha731
in response to christophers's comment.
by
fatha731
in response to christophers's comment.
You go to your profile here on Talk an click on your avatar. Then you insert your old username and password. I'm sure you can go on from there. 😃
Posted
-
 by
turelli
by
turelli
Seeing possible comments made on my own comments
How can I see if somebody has made a remark after a comment of mine?
thank youPosted
-
 by
ElisabethB
moderator
by
ElisabethB
moderator
You can follow a thread or discussion and then you can check these followed threads by clicking on 'following'.
That is the only way I can see.
Posted
-
 by
fatha731
by
fatha731
...or one could go to his profile and check his recent comments and discussions and check the one he's interested in.
Posted
-
 by
turelli
by
turelli
thank you both!
Posted
-
 by
ElisabethB
moderator
by
ElisabethB
moderator
Well, that is what we get paid for !!! Oh wait, ;-d ;-d
No, it's just because we love doing this ! I can still remember when I was a newbie and everything was so, well new !
Happy hunting everyone ! 😄
Posted
-
 by
LeeKick
by
LeeKick
Hi, my little problem is, that the quality of the pictures could be much better..., and when I click the help button, I can unfortunately not see all the page.., can see just the upper part.. wich is a pitty, because of course it could be very helpful to see those examples.My Screen is having the highest resolution already.
Posted
-
 by
ElisabethB
moderator
by
ElisabethB
moderator
Hi LeeKick,
which browser are you using? We know from experience that IE "sucks". Chrome and Firefox are definitely okay.Posted
-
 by
LeeKick
by
LeeKick
Hi, I m using mozilla firefox... But ok, I will try it with another browser. Thanks 😃
Posted
-
 by
fatha731
by
fatha731
I'm perfectly fine with Safari, if that's easier for you.
Posted
-
 by
LeeKick
by
LeeKick
Try it right now with g. chrom.. not perfect, but ok.. But: Thanks 😃
Posted
-
 by
HelPer2
by
HelPer2
Hi, I just returned to galaxyzoo after a summer break. I cannot sign in using google chrome (I've reset my password and IE works fine). Also, the classify and talk pages do not load; I just get the header on classify, and the footer on talk. Any ideas that may help me return to my preferred browser?
Thanks.Posted
-
by skyandcosmos
Wow !!!
In addition, Galaxy Zoo participants discovered many mysterious objects like Hanny's Voorwerp ~ http://apod.nasa.gov/apod/ap110210.html !!!
Posted
-
 by
odin234
by
odin234
ty xD this help me a lot, i was confuse when i saw this one http://skyservice.pha.jhu.edu/DR8/ImgCutout/getjpeg.aspx?ra=12.89918158&dec=12.79247522&scale=0.79224&width=1012&height=1012&opt=&query=
Posted
-
 by
vrooje
admin, scientist
by
vrooje
admin, scientist
I'm glad it helped! 😃
-Brooke
Posted
-
 by
jrgdavies
by
jrgdavies
How do I access my Favourites on the new Galaxy Zoo?
jrgdavies@yahoo.caPosted
-
 by
ElisabethB
moderator
by
ElisabethB
moderator
You can find your favourites under Profile.
Posted
-
Hello, I want to know how do you know that I classified some galaxies, regards.
Posted
-
 by
ElisabethB
moderator
by
ElisabethB
moderator
Hi rickyespinosa
All our classifications are collected and stored. Every time you click, your answer is recorded.
Posted
-
 by
MrsRobbins
by
MrsRobbins
Is there any way to keep track of how many spirals vs. smooth, and "odd" vs. "normal"? I know the PROFILE page shows some info but I was looking for tallies of some sort. My students are working on Galaxy Zoo and I want them to include it in their project. Thanks
Posted
-
 by
ElisabethB
moderator
by
ElisabethB
moderator
Hi Mrs Robbins
I forwarded your message to the science team.
Great that you have your students involved in Galaxy Zoo !
Happy hunting !
Els
Posted
-
 by
Wisi_EU
by
Wisi_EU
Just thought I'd post this URL here... it could be possibly very useful to all beginners here, specially to understand the importance of redshift and the possibility of blueshift. http://skyserver.sdss.org/dr1/en/proj/basic/universe/redshifts.asp
CheersPosted
-
 by
ianbach
by
ianbach
Thanks I just joined and this was a very helpful post can you give examples of nebula and gas clouds also?
Posted
-
 by
Wisi_EU
by
Wisi_EU
Here are types of galaxies to help you classify them (from the original Hubble classification system) http://sings.stsci.edu/Publications/sings_3col/sings_3col.jpg
@ianbach, this is to give information on nebulae type of clouds http://www.sttff.net/ast/AST_nebulaclassification.html , but due to the nature of the pictures from SDSS and UKIDSS, you won't be able to see many nebula and gas clouds directly.
I would also advise you have a quick look at these pages from SDSS if you're a starter 😉 http://skyserver.sdss.org/dr1/en/astro/stars/stars.asp
😄
Posted
-
it is my first time on galaxy zoo and i have been classifying images for an hour and i'm not pretty sure if i'm doing this right...but this was very helpful thank you
Posted
-
 by
G.Heberlein
by
G.Heberlein
Great Forum. This is a great site and it is always a good time to stop in and classify some new sights. Thank You for all your hard work.
Posted
-
 by
Jenszooni
by
Jenszooni
I am so new to Galaxy Zoo but it's wonderful. If I click "favourite" at the right hand side of the pictures, are they saved somewhere for me to see again? Still finding my way around the website and need to read a lot more about how to do this!
Posted
-
 by
Capella05
moderator
in response to Jenszooni's comment.
by
Capella05
moderator
in response to Jenszooni's comment.
Hi and welcome Jenszooni,
Yes they are saved, over on Galaxy Zoo.
If you look at the top of the screen, there is a 'Profile' hyperlink on the right. Click on that.
Now click on the 'Favourites' hyperlink on the left hand side.Let me know if this works!
Capella.
Posted
-
 by
xantipa
by
xantipa
Hi,
as I have only 500 classifications I suppose here is the place to find answers to my beginner's questions:
- There is some erratic link about a quiz; where is it now; I wanted to do it in tha latest time but dissapeared.
- How many clicks should I collect in order to see some "Hubble Galaxies"?
- In the talk profile the only preferencies I can change is the Time format (absolute or relative). This is a bug or a feature?
Thanks
Posted
-
 by
Capella05
moderator
in response to xantipa's comment.
by
Capella05
moderator
in response to xantipa's comment.
Hi and welcome @xantipa 😃
To answer your questions:
- Ignore the quiz pop-up - it is a retired 'feature' 😃
- The Hubble survey has been completed - since then we have done the UKIDSS and reverted back to SDSS. We have a exciting new survey coming up later this year - so watch the GZ blogs / social media / twitter or Talk for details 😄
- That is all you can currently configure - we will have a new version of talk launching next year, so it should be more customisable
Hope this helps 😃.
Posted
-
 by
ElisabethB
moderator
by
ElisabethB
moderator
And congrats on your 500 classifications !
Every click counts ! 😄
Happy hunting !Posted
-
 by
Budgieye
moderator
by
Budgieye
moderator
You can see Hubble images in the old Forum: Galaxy Zoo: Hubble forum http://www.galaxyzooforum.org/index.php?board=33.0 A mini-forum, where Hubble images have been posted.
Posted
-
 by
NynkS2
by
NynkS2
So, are all pictures that have bright green/pink colours stars and not galaxies?
Posted
-
 by
Capella05
moderator
in response to NynkS2's comment.
by
Capella05
moderator
in response to NynkS2's comment.
Hi NynkS2 😃
Not having an image to look at, it sounds like you are describing foreground stars - sometimes there are problems with the filter on the telescope and we land up having some pretty spectacular artefacts to classify 😃
Posted
-
 by
stefku
by
stefku
Hi there
I'm new and I've got some questions.
- Yesterday, I found a thread in the forum where I an ask newbee questions. I'm not able to find it anymore. The search is not working without login, but my login doesn't work. Anybody a hint what I'm doing wrong? I thought the login for the forum is similar to login to galaxyzoo.
- How do I distinguish stars from round galaxies? Maybe thats a topic for the help above on this thread.
- Skyserver already seems to know if an object is a star or a galaxy. Is this information right? If yes, why do I have to decide again?
Thanks in advance 😃
Posted
-
 by
Capella05
moderator
in response to stefku's comment.
by
Capella05
moderator
in response to stefku's comment.
Hi and welcome @stefku 😃
It is always good to have questions - I will do my best to answer them 😃
- The old forum is now an archive, you can still read all the old threads and posts, but you are unable to enter new ones. If you have a question related to a object, or even a general question post it here and someone will get back to you 😃
- Stars tend to be more cleanly defined than galaxies. To use a technical term - galaxies are more fuzzy 😃 Stars also have a few artifacts associated with them - these are caused by imaging 'errors' - they can have garish colours and diffraction spikes etc... If you have some examples you would like our opinion on - do post them!
- SkyServer is not always correct - they do try to be - but I have seen stars tagged as galaxies and visa versa. Always use your eyes first 😃
Hoped this helped! 😃
Posted
-
 by
stefku
in response to Capella05's comment.
by
stefku
in response to Capella05's comment.
Thanks @Capella05, that helps 😃
- Unfortunately, I cannot discuss an object until I classified it. Or is there another possibility?
Posted
-
 by
Capella05
moderator
in response to stefku's comment.
by
Capella05
moderator
in response to stefku's comment.
Unfortunately not 😃 We want to get your opinion on the object. If you had a chance to discuss it, or read other volunteers opinions, the study would be biased.
Posted
-
 by
Lyntessa.May_
in response to vrooje's comment.
by
Lyntessa.May_
in response to vrooje's comment.
In the last group of these galaxies the first three images look like they could all be the same galaxy from different angles. We only have our singular view from Earth and therefore I do not think they really are the same galaxy just that their shapes are similar. Looking at galaxies on end gives us a different view than looking at the top or a diagonal view of them. This is important in trying to determine what type of galaxy it is.
Posted
-
 by
Marie_Em
by
Marie_Em
It is nice finally to understand what I sometimes can see on the screen. I have to sy that I was a bit stressed about make it wrong.
Thx so much 😃Posted
-
 by
DZM
admin
by
DZM
admin
Welcome, Marie! Don't be stressed. 😃 Each image is classified by many people, so mistakes aren't a problem. And when it's unclear what an object is, take your best guess! We've found that the cumulative effect of many people's guesses often helps us find the right answer.
Again, welcome, and happy classifying! Hope to see you around Talk plenty!
Posted
-
 by
Vishal_Arora
by
Vishal_Arora
Thank You very much for the information vrooje 😃
Posted
-
 by
Krystle
by
Krystle
Hey everyone!
Apologies in advance for my newbie questions, I hope I'm in the right spot!
Is there any way to skip a galaxy?
What's SDSS and how come I can't click it? Screenshot: http://screencast.com/t/tF2x5gGZLXJ
Thank you 😃
Posted
-
 by
DZM
admin
by
DZM
admin
Hi @Krystle!
No, there's no way to skip a galaxy. We want people to classify whatever they see, even if it just means taking their best guess... and we want to make sure that people can't just skip until they find a cool one that they like. 😃 We need all of these classified, not just the cool-looking ones, and even the difficult ones! Don't worry if you're unsure; educated guessing is sometimes a core element of citizen science.
SDSS refers to the Sloan Digital Sky Survey. I'm not 100% sure, but I think that the icon denotes that the image you're looking at came from the SDSS, and not the Hubble... ? It's just an indicator, not a link.
Thanks for asking!!
Posted
-
 by
ElisabethB
moderator
by
ElisabethB
moderator
Hi Krystle
Re : SDSS refers to the Sloan Digital Sky Survey. I'm not 100% sure, but I think that the icon denotes that the image you're looking at came from the SDSS, and not the Hubble... ? It's just an indicator, not a link.
DZM is correct. In an earlier stage there were also images from Hubble so the icon changed according to where the image was coming from.
Hope this helps.
Happy hunting ! 😄
Posted
-
 by
ibrahim717
by
ibrahim717
thank you
Posted
-
 by
Alpha2087
by
Alpha2087
May i ask a novice question : is it possible, from an galaxy image, to know if there is one more hi-res image from HST or other telecsope ?
example : http://talk.galaxyzoo.org/#/subjects/AGZ0002q92
thank'sPosted
-
 by
ElisabethB
moderator
in response to Alpha2087's comment.
by
ElisabethB
moderator
in response to Alpha2087's comment.
Hi Alpha2087 and welcome to the Zoo
Here is a very good guide on how to find out more about your galaxy : http://talk.galaxyzoo.org/#/boards/BGZ0000005/discussions/DGZ0000lv2
Happy hunting ! 😄
Posted
-
 by
Capella05
moderator
in response to ElisabethB's comment.
by
Capella05
moderator
in response to ElisabethB's comment.
Expanding on what Els has said, once you have the ID of the galaxy, use a search engine to find other images of it 😃
Posted
-
 by
Jellogum
by
Jellogum
Hi, My name is Jeremy. I am working to meld games with open source projects and education. For example, I am developing some software called GISZoo and GISCell, which in time will dovetail some features of Zooniverse with my project. I am here to explore how to infuse various Zooniverse projects into my game. I am also trying to convince Star Citizen developers that aspects of their game should include Zooniverse projects to enhance in-game play while helping to promote the goals of Zooniverse projects.
Can someone offer a contact that I can use to discuss if it is possible to meld software between my project and Zooniverse?
Posted
-
 by
Capella05
moderator
in response to Jellogum's comment.
by
Capella05
moderator
in response to Jellogum's comment.
Hi Jellogum 😃
You could try Darren, the community manager - darren@zooniverse.org
Posted
-
 by
mikorangester
in response to vrooje's comment.
by
mikorangester
in response to vrooje's comment.
Hi
What is the SDSS button in the classify app?Posted
-
What is the SDSS button in the classify app for?
Posted
-
 by
Budgieye
moderator
by
Budgieye
moderator
That is a good question.... What is the function of the SDSS button in Classify? Maybe it just tells us the source of the image? ie SDSS
Posted
-
 by
Budgieye
moderator
by
Budgieye
moderator
Hovering the mouse over the examples on page 1 is not working for me. Chrome, Windows Vista
Posted
-
 by
ElisabethB
moderator
in response to mikorangester's comment.
by
ElisabethB
moderator
in response to mikorangester's comment.
Hi mikorangester and welcome to the Zoo
Budgieye is right. At one time there were also Hubble images thrown in the mix and that way people knew from which survey the image was.
Posted
-
 by
DZM
admin
in response to Capella05's comment.
by
DZM
admin
in response to Capella05's comment.
Yes; incidentally, I've told Jeremy in many places that he can reach out to me, though I haven't seen anything from him yet.
And yes, for @mikorangester , these days we only have SDSS images, so every image will be marked SDSS. It's just a marker, not a button. Good question!
Posted
-
 by
logic52
by
logic52
I have only just started to classify galaxies. I have found all the above questions and answers very helpful. I recently had an image that has six galaxies on it. I was only able to comment on one. How does one comment on multiple galaxies, or is the requirement to comment on the major one in the image?
Posted
-
 by
DZM
admin
in response to logic52's comment.
by
DZM
admin
in response to logic52's comment.
Hi @logic52 -- welcome to Galaxy Zoo! Glad we're helping you out. 😃
When there are multiple galaxies, you only want to classify the one in the very center. The rest are vestigial, although you could comment upon them if you wanted to.
Hope this helps. Thanks for your effort!!
Posted
-
 by
Budgieye
moderator
by
Budgieye
moderator
More examples are needed on the classification page. A new classifier was confused about if an elliptical was clumpy with one lump.
Clumpy galaxies need a lot of magnification to be seen. I can see a clumpy galaxy above the target galaxy. They are blue and have an irregular shape. The zoomed in images look more pixellated. The target galaxy in the center of the image is closer to us, so it appears larger and needs a zoomed out image. It looks like an edge-on galaxy, with a bulging nucleus. So I would classify as
Features or disk, clumpy -no, Could this be a disk viewed edge-on? yes, rounded bulge, anything odd-no.
I will suggest that there should be more examples on the classification page.
Ellipticals are blobs from any direction, shaped like a rugby ball, American football, watermelon, avocado, .. take your pick. If you see them from one side, they are completely round, if you see them from the another, they are in-between. Ellipticals are never cigar shaped. If you see something long and thin with no detail, you are seeing an distant edge-on galaxy that has no nuclear bulge.
Here is an example of an inbetween shaped elliptical.

http://talk.galaxyzoo.org/?_ga=1.231298393.711441289.1371287491#/subjects/AGZ0002xie
Having a nucleus doesn't count as detail.
Posted
-
 by
KiranClarke
by
KiranClarke
How do I get to look at Hubble images instead of SDSS?
Posted
-
 by
ElisabethB
moderator
in response to KiranClarke's comment.
by
ElisabethB
moderator
in response to KiranClarke's comment.
Hi KiranClarke and welcome to the Zoo
The Hubble images are all classified so we're, for the moment, back to the SDSS ones. But we are waiting for some new catalogues to classify.
Hope this helps
Happy hunting !
Posted
-
 by
mlpeck
in response to KiranClarke's comment.
by
mlpeck
in response to KiranClarke's comment.
@KiranClarke you might be interested in the "Galaxy Zoo: Bar Lengths" project. It's using Hubble images -- I think from CANDELS.
Posted
-
 by
Ktrip
by
Ktrip
I can barely use the net, much less twitter, which I suppose are the hash tags. So I will just put notes on discussions for someone else to pick up. If I just write the #etc note on it, will it work for you? where are a list of these #s and their descriptions for the uninitiated?
Posted
-
 by
Ktrip
by
Ktrip
How can we check on the comparable accuracy of our classifications if we are new to this?. I have moderate astro knowledge, but may have missed some terms.
Posted
-
 by
ElisabethB
moderator
in response to Ktrip's comment.
by
ElisabethB
moderator
in response to Ktrip's comment.
Just check here in Talk ! 😄 And for some images there is no right or wrong. That is why they need us ! 😄
Just answer the questions as well as you can !
Happy hunting ! 😄
Posted
-
 by
ElisabethB
moderator
in response to Ktrip's comment.
by
ElisabethB
moderator
in response to Ktrip's comment.
Sorry, but there are no lists of #. Just look to the left and look at the posts that people post. I know this will sound really corny? But in fact, the classifications work out really good ! 😄
Posted
-
 by
BeaterGirl
by
BeaterGirl
Oh, thanks. I've been believing all that strange green stuff what's actually bad-viewed stars was photos of galaxies.
Posted
-
 by
thargos
by
thargos
Excellent original post. Thanks.
Posted
-
 by
bryankile1210
in response to vrooje's comment.
by
bryankile1210
in response to vrooje's comment.
Thanks for the info page. I am brand new to the site, I saw the talk on TED and had to check it out. I have no idea what I am doing so any advice would be great. Like, what do the terms next to each image mean. The RA. DEC, Redshift, log(Mstar), and Pbar? I am a complete newbie, help me out please. Point me at the right documents to read, or something.
Much appreciatedPosted
-
 by
Budgieye
moderator
by
Budgieye
moderator
Try
#1 How do I : Find out more information about the galaxy I have classified? http://talk.galaxyzoo.org/#/boards/BGZ0000005/discussions/DGZ0000lv2
For RA, DEC Examine, Skyserver, Finding Chart, navigate, NED
for redshift, try
Astrophysics for Galaxy Zoo Talk - redshift z PhotoZ spectra emissions AGN https://talk.galaxyzoo.org/#/boards/BGZ0000001/discussions/DGZ0000ulp
Posted
-
 by
ratprincess
by
ratprincess
Could we get feedback on our classification somehow? Think it might enhance the validity (whatever it might mean in the classification context) of the classification outcome and to avoid being reliably wrong?
Thanks.
Posted
-
 by
Budgieye
moderator
by
Budgieye
moderator
I will try to answer for the scientists. Nobody knows how they do on classification. It ruins the statistics gathered, if information is given out. A classifier gets better with practice, and his/her classifications get a higher reliability score, but no one ever finds out what is it.
by klmasters ADMIN, SCIENTIST
One way you can get some feedback if you wish to is to classify in a group (it can be a group of one person) and then use the Navigator tools to explore the galaxies you've classified in a group. This is a tool we've found to be popular with educators, but is available to all.Try it out here: http://www.galaxyzoo.org/#/navigator/home
Posted
-
 by
ratprincess
in response to Budgieye's comment.
by
ratprincess
in response to Budgieye's comment.
OK. I see. Thanks!
Posted
-
 by
thinhnh3009
by
thinhnh3009
Is there any certificate or anything that certifies the users's contribution (such as paper, post..) ?
I'm new in Galaxy Zoo, Thanks a lot.
Posted
-
 by
lerellhoward
by
lerellhoward
good job
Posted
-
 by
aerodavew
by
aerodavew
Newer classifiers NEED MORE EXAMPLES OF EVERYTHING!!!
Posted
-
 by
Arcsecs
by
Arcsecs
I am having a problem with my collection. I keep getting multiple copies in there and if I delete one they all go. The collection feature would be so good if it was easy to find and use.
Posted
-
 by
WGFinCO
by
WGFinCO
Just started classifying recently - enjoyable. Would it be possible to move the Examples screens and their enlargements to the right of the image of the galaxy being classified, or make them dragable to the right, to permit a more side-by-side comparison?
Thanks.Posted
-
 by
ElisabethB
moderator
in response to WGFinCO's comment.
by
ElisabethB
moderator
in response to WGFinCO's comment.
Sorry, I don't think these rearrangements are possible in this phase of the project. Maybe they will be taken into account when the project will move to the Panoptes environment.
Thanks for participating ! 😄
Posted
-
 by
zoob1172
by
zoob1172
There is a project proposal to do this.
Posted
-
tnx
Posted
-
 by
shocko61
by
shocko61
Hi all , I came across a galaxy that looks square the Id: 588017603611263006 . The shape is a bit funny .
Posted
-
 by
Budgieye
moderator
by
Budgieye
moderator
Is this the galaxy that you mean?
http://cas.sdss.org/dr7/en/tools/explore/obj.asp?id=588017603611263006
Posted
-
 by
Bazilou_defender
in response to vrooje's comment.
by
Bazilou_defender
in response to vrooje's comment.
Thanks very much Brook
A great help to my 11 yr old son and I who have just started. Enjoying the classifying of images together. Interestingly, he is far more decisive about what he sees immediately.
We have alreay commented on 2 images, one which us a formless blue cloud and another a spiral galaxy with a detached cloud like part. Would appreciate comments from more experienced participants.
Thx againPosted
-
 by
vrooje
admin, scientist
in response to Bazilou_defender's comment.
by
vrooje
admin, scientist
in response to Bazilou_defender's comment.
Thanks so much for classifying!
We have several really experienced classifiers (including our moderators) who comment when people ask questions, but sometimes it's hard to keep up. Sorry if we missed yours! 😃 But don't worry, your classifications will be useful no matter what.
Posted
-
 by
LimaZulu
by
LimaZulu
The "gamma" option doesn't work for me, as in it does exactly NOTHING. Have tried it in many pics with no luck. Am using a machine running Windows 10 version 1703 ( because the last version jacked up things, I am holding off on the most recent update)build 15063.726 and Firefox version 57.0 (again, holding off on updates since I HAAAAAATED the Quantum update. The Creator version was so much better)
Posted
-
 by
Budgieye
moderator
by
Budgieye
moderator
Sorry, what do you mean by "the gamma option" ?
Posted
-
 by
Budgieye
moderator
by
Budgieye
moderator
Some of my helpful hints for
BEGINNERS
There is no correct answer. If there are many different answers, it shows that this galaxy is difficult to classify, and that is information in itself.
Please see the comments under your own. Hopefully the next version of Talk will not have them hidden low on your screen.
New to Galaxy Zoo? Want Help? Read this!
http://talk.galaxyzoo.org/#/boards/BGZ0000003/discussions/DGZ1006byhSee something strange? Zoom out in SDSS Navigate and see if other stars are affected.
#1 How do I : Find out more information about the galaxy I have classified? http://talk.galaxyzoo.org/#/boards/BGZ0000005/discussions/DGZ0000lv2
#1 How do I : Find out more information about the galaxy I have classified? http://talk.galaxyzoo.org/#/boards/BGZ0000005/discussions/DGZ0000lv2
Examine, Skyserver, Finding Chart, navigate, NED#2 How do I: A Talk Tutorial http://talk.galaxyzoo.org/#/boards/BGZ0000005/discussions/DGZ0000utn
In this thread you will learn (in no particular order) :
How to create / edit discussions (known as Threads on the old Forum)
Add comments / use the recents tab
Create / edit and add items to collections
Send PM’s and edit your Zooniverse profile
Follow threads and comments
Use the search functionality
Find your way around your Talk profile.#3 How do I: All your FAQ's - Includes a GZ Glossary
http://talk.galaxyzoo.org/#/boards/BGZ0000005/discussions/DGZ0000x8e
Where can I change my avatar?
How do I post a picture?
How do I post a hyperlink?
Where can I find my favourites that I have classified?
In what context are these terms used?
Artifact
Oversaturation
Foreground star
Diffraction Spike
Overlap
Merger
FOV
SkyServer
AGN
Asteroid
Satellite Trail
Satellite Galaxy (not to be confused with the above)
NED
SIMBAD
SDSS
UKIDSS
Starbursts / Star Formation
Irregular
Disturbed
Low Surface Brightness Galaxy (LSB)Objects that need more research https://talk.galaxyzoo.org/#/boards/BGZ0000004/discussions/DGZ0000ycq
SUPERNOVA
supernova are small and green see 4.1 Supernova https://talk.galaxyzoo.org/#/boards/BGZ0000001/discussions/DGZ0000wrb?page=4
Unreported supernova #SNe https://talk.galaxyzoo.org/#/boards/BGZ0000007/discussions/DGZ00016qcIs it a supernova? Check transients with Aladin https://talk.galaxyzoo.org/?_ga=2.197780399.1487098012.1493877526-711441289.1371287491#/boards/BGZ0000007/discussions/DGZ0002gsd
GRAVITATIONAL LENS
Zooite Guide to Strong Gravitational Lenses http://www.galaxyzooforum.org/index.php?topic=275811.0
Gravitational lenses https://talk.galaxyzoo.org/#/boards/BGZ0000001/discussions/DGZ0000wrb?page=3Gravitational lenses https://talk.galaxyzoo.org/#/boards/BGZ0000001/discussions/DGZ0000wrb?page=3
JETS
Relativistic jets are tiny features seen in a few nearby galaxies. Here is information.
3.6 relativistic jets in optical and radio https://talk.galaxyzoo.org/#/boards/BGZ0000001/discussions/DGZ0000wrb?page=3
examples of jets here http://talk.galaxyzoo.org/#/boards/BGZ0000001/discussions/DGZ0000wrb?page=3&comment_id=53d8b92adb90c76710000f93DISTANCE
These galaxies are probably well spaced out 😃 The blue one is probably closer to us that it is to the yellow ones. The orange one is quite distant.
Forum: Friday 8th January, 2010. Two galaxies, the same size? by Budgieye http://www.galaxyzooforum.org/index.php?topic=277034.msg416504#msg416504 measure the size and distance of two galaxies
PAGE 2 Galaxy Redshift Chart https://talk.galaxyzoo.org/#/boards/BGZ0000007/discussions/DGZ0000ulp?page=2
7.3 Measure distance https://talk.galaxyzoo.org/#/boards/BGZ0000001/discussions/DGZ0000wrb?page=7
ADVANCED
Index for Galaxy Zoo Talk (links and images ) https://talk.galaxyzoo.org/#/boards/BGZ0000001/discussions/DGZ0000wrbGalaxy Redshift Chart https://talk.galaxyzoo.org/#/boards/BGZ0000007/discussions/DGZ0000ulp?page=2
Galaxy Redshift Chart https://talk.galaxyzoo.org/#/boards/BGZ0000007/discussions/DGZ0000ulp?page=2Spectra guide for SDSS images in Galaxy Zoo Talk https://talk.galaxyzoo.org/#/boards/BGZ0000001/discussions/DGZ0000ulp?page=3&comment_id=53fef2ee3d5a77490c0001b6
Unknown / No ObjID in SDSS https://talk.galaxyzoo.org/?_ga=1.191070186.1751955194.1484309494#/boards/BGZ0000005/discussions/DGZ0002m2r
Changing size of an image
by Ghost_Sheep_SWR
I recently started using this:
When adding an image, just add '=300x' or '=300x300' directly behind jpgPosted